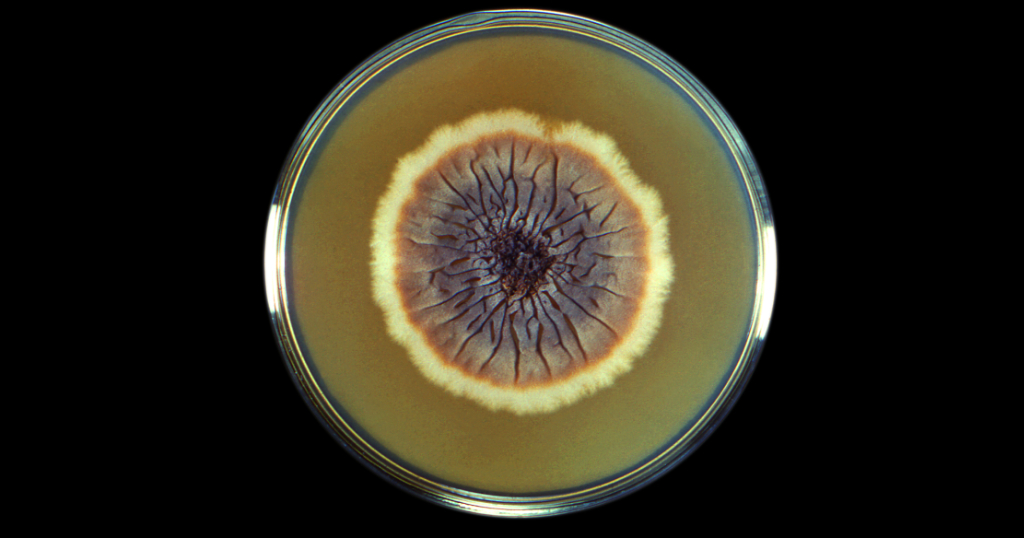

Publicado originalmente em Jornal da USP. Acesse na íntegra aqui.
A esporotricose é a micose subcutânea mais prevalente no mundo, sobretudo em áreas tropicais e subtropicais. A infecção é causada por um fungo e se manifesta por meio de lesões na pele, podendo também causar feridas na mucosa oral e ocular. Sua principal forma de transmissão é por arranhões e mordidas de gatos domésticos infectados, e casos mais graves ocorrem em pacientes imunodeprimidos.
Dos 27 estados do Brasil, 26 apresentam diagnósticos confirmados, e o Rio de Janeiro é considerado o epicentro da doença. Em 2023, 1.239 casos foram registrados no País, e mais 945 casos foram notificados até junho de 2024, caracterizando uma epidemia. Apesar da disponibilidade de tratamento no Sistema Único de Saúde (SUS), a doença ainda não é plenamente identificada: apenas no último dia 30 de janeiro a notificação da esporotricose se tornou obrigatória.
Nesse cenário, pesquisadores da USP publicaram um artigo de perspectiva para chamar a atenção para a reemergência dessa doença. “As doenças fúngicas, de forma silenciosa, vêm se tornando um problema, […] e são subestimadas em relação às doenças bacterianas e virais”, comenta, ao Jornal da USP, Carlos Aguiar, médico veterinário e doutorando no programa de Ciência e Tecnologia de Alimentos da Escola Superior de Agricultura Luiz de Queiroz (Esalq) da USP. Além da ausência de vacinas disponíveis para prevenção, os antifúngicos existentes são extremamente limitados e, no caso da esporotricose, demandam três a seis meses de tratamento.